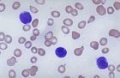
Bkaba.jpg

未使用文件
来自医学百科
下面为未被任何页面使用的文件。请注意,其他网站可能会通过URL直接链接某个文件,因此列表中的文件有可能仍在使用。
下面显示区间#3,251至#3,300的50条结果。
查看(前50个 | 后50个)(20 | 50 | 100 | 250 | 500)
- Gq0p734m.jpg 201 × 407;15 KB
- Bk1rr.jpg 500 × 402;48 KB
- Bkmod.jpg 465 × 700;121 KB
- Bk3yc.jpg 422 × 312;24 KB
- Bk4m4.jpg 100 × 120;3 KB
- Gv7ry0jk.jpg 333 × 237;7 KB
- Bkaba.jpg 140 × 91;4 KB
- Gumvuaph.jpg 403 × 195;11 KB
- 56612855.jpg 400 × 400;27 KB
- Gumd1f82.jpg 277 × 268;7 KB
- Bk6mb.jpg 500 × 500;85 KB
- Bk54r.jpg 371 × 182;23 KB
- Gxpslqv1.jpg 553 × 276;16 KB
- Gum5nim3.jpg 711 × 240;15 KB
- Gunt6a1s.jpg 335 × 325;38 KB
- Bkkzz.jpg 139 × 140;4 KB
- Bkb4x.jpg 139 × 80;2 KB
- Gj6wp83o.jpg 261 × 220;12 KB
- Gl0yq88e.jpg 651 × 474;26 KB
- Bk5xs.jpg 204 × 283;12 KB
- Bk5se.jpg 709 × 423;15 KB
- Bk1c9.jpg 340 × 226;27 KB
- Bkptd.jpg 140 × 87;4 KB
- Bkpeo.jpg 247 × 179;11 KB
- Gxq0d49w.jpg 332 × 585;58 KB
- Gq0q7301.jpg 37 × 37;896字节
- Guwfmi8u.jpg 262 × 364;19 KB
- Gxq4f5tn.jpg 236 × 340;7 KB
- Jiatingyixuebaike zijiuhujiu114.jpg 264 × 108;8 KB
- Bk8ll.jpg 600 × 600;28 KB
- Bk02b.jpg 450 × 338;42 KB
- H1g35e8z.jpg 120 × 92;3 KB
- Bk7x5.jpg 139 × 118;5 KB
- Bkhh3.jpg 204 × 145;40 KB
- Bk0ea.jpg 509 × 665;36 KB
- Gj5xl2sl.gif 200 × 222;5 KB
- Gj5s3c0h.jpg 274 × 204;21 KB
- H88lfc33.jpg 8 × 16;669字节
- Bkjw9.jpg 460 × 320;24 KB
- Bkmej.jpg 480 × 360;36 KB
- Bk9nd.jpg 145 × 200;9 KB
- 58982768.jpg 500 × 347;59 KB
- Bkjmz.jpg 128 × 96;5 KB
- Bk829.jpg 400 × 459;61 KB
- Bkm2u.jpg 407 × 450;26 KB
- Gl0pa7bj.jpg 329 × 164;5 KB
- Bk4in.jpg 400 × 231;58 KB
- Bk0te.jpg 300 × 225;8 KB
- Bkm5g.jpg 200 × 130;2 KB
- Bk0ie.jpg 500 × 500;43 KB